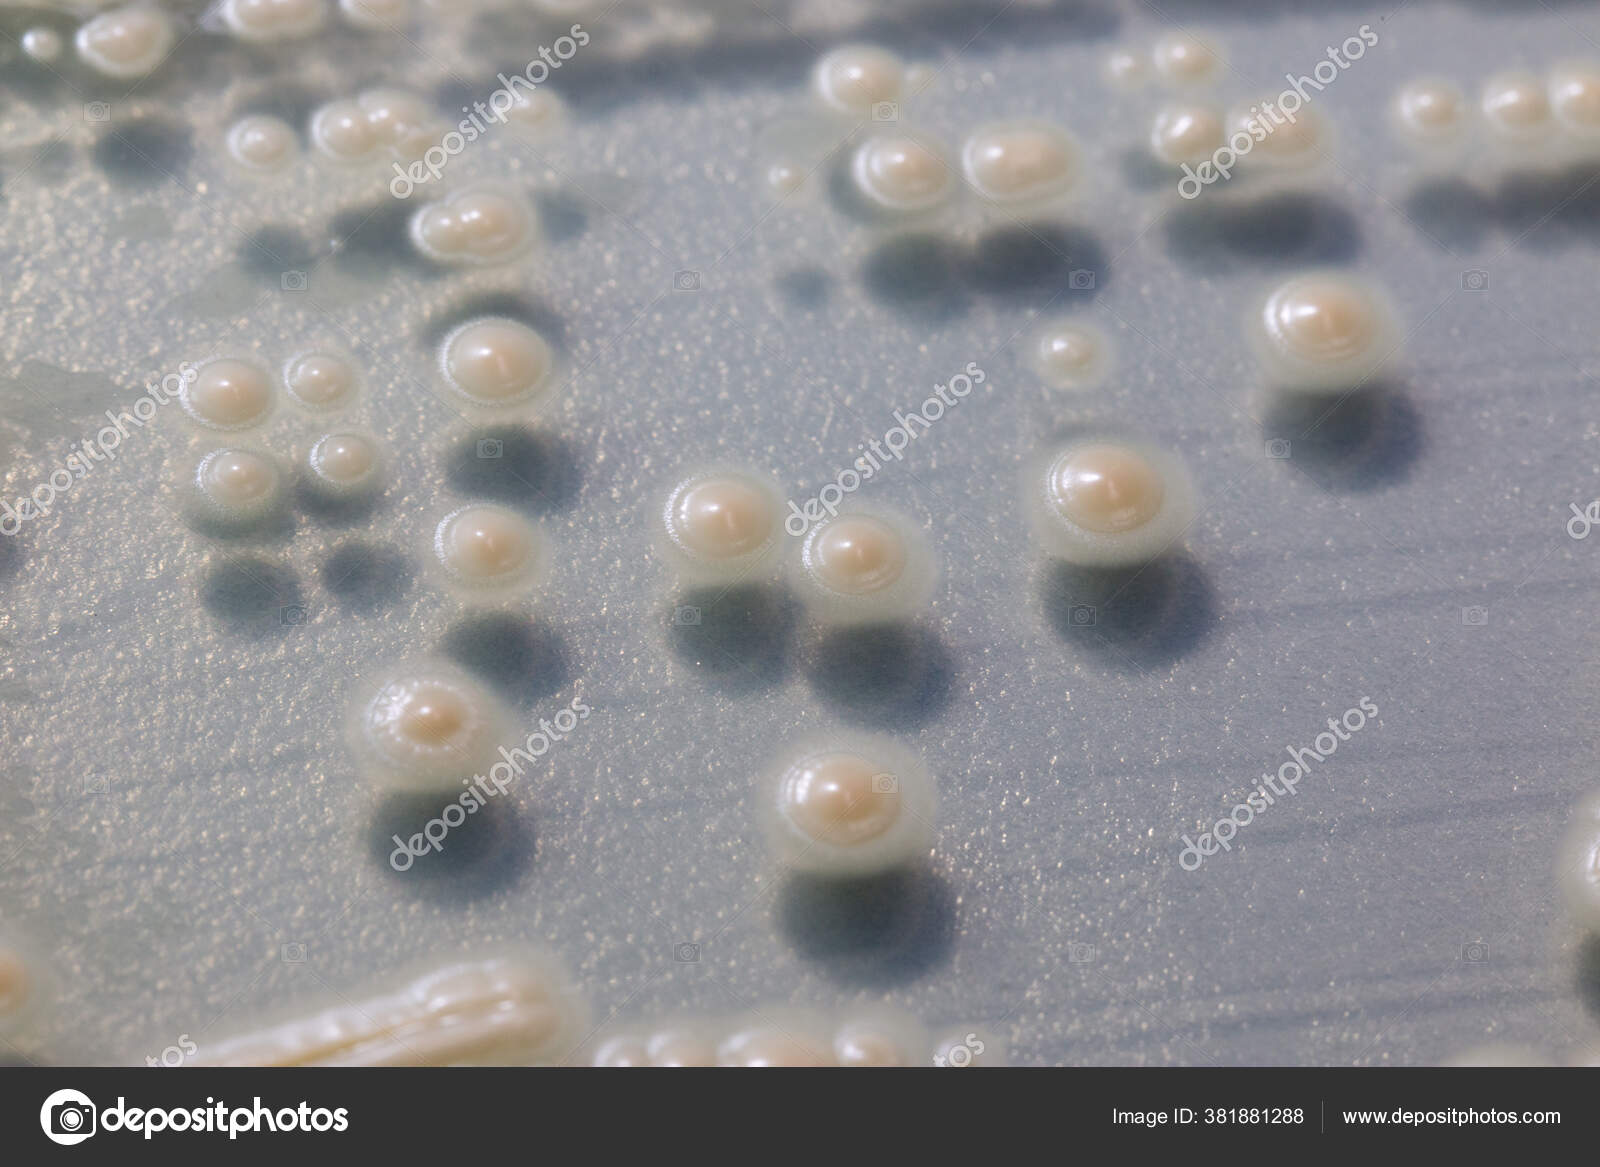

Yeast Cells Under Microscope
Saccharomyces cerevisiae yeast budding cell under the microscope Yeast sample under the microscope Under the microscope are yeast of the genus saccharomyces Magnification X400.

Yeast cells under microscope. Mix 1 g of powder in 1 L of water Take a sample of beer or yeast slurry in a flask and, if necessary, dilute it with distilled water until you have a sample that contains ~100–0 cells in the microscope viewing field Mix the sample thoroughly Then pipette out about 2–4 mL and place it in another flask. • Wet mount A sample of the vaginal discharge is placed on a glass slide and mixed with a salt solution The slide is looked at under a microscope for bacteria, yeast cells, trichomoniasis (trichomonads), white blood cells that show an infection, or clue cells that show bacterial vaginosis. If we were to view yeast cells under a microscope, those yeast cells would not be alive If we were able to view live yeast under a microscope, what we'd see would be too small even at the highest magnification setting to allow us to see any parts of the yeast cells Explore the structures and functions of the parts of a yeast cell in the animation.
When we look at the yeast under the high power microscope, we will see that it has numerous microscopic bodies that are shaped like an egg These bodies that make up the yeast are yeastplants that have a single cell They are units of protoplasm that contain nucleus, globules of oil, vacuoles and are enclosed by a cell wall. Examination of the discharge under a microscope is the simplest and least costly method used for diagnosis of yeast infection, but this test may be negative in up to 50% of women who have a yeast infection In some cases, the doctor may administer a Pap test to rule out the possibility of cervical dysplasia or cancer. Yeast refers to a microscopic fungus, consisting of single oval cell that reproduces by budding, and converts sugar into alcohol and carbon dioxide in a process called ethanol fermentation Generally, yeast is colorless Though it is a unicellular organism, yeast is a eukaryote Therefore, it contains a nucleus and membranebound organelles.
A yeast cells swell more when they absorb stains b yeast cells are eukaryotic c yeast cells have multiple nuclei d yeast cells have extremely thick cell walls. • Wet mount A sample of the vaginal discharge is placed on a glass slide and mixed with a salt solution The slide is looked at under a microscope for bacteria, yeast cells, trichomoniasis (trichomonads), white blood cells that show an infection, or clue cells that show bacterial vaginosis. Yeast sample under the microscope Under the microscope are yeast of the genus saccharomyces Magnification X400 You can see dividing cells and nuclei.
Yeast Cells Under the Microscope I was looking at some baker's yeast underneath a microscope and managed to get this shot through the eyepiece with my phone I'm not entirely sure how it managed to have such a dark background (probably a combination of the microscope's diaphragm and my phone's auto white balance), but I think it came out pretty. Author Gregory S Pryor Created Date 8/30/16 PM. Diagram Yeast Cell Under Microscope Written By MacPride Wednesday, March 14, 18 Add Comment Edit Yeast Fermentation Of Sugarcane For Ethanol Production Can It Be Cells Of V2 Yeast Isolate Under Microscope X100 Download Interactive Zooming In On Yeast.
The size of the bud, which will become the daughter cell, continues to grow until the cells divide in M phase When the cell divides, the daughter cell is still smaller than the mother cell The daughter cell will need to grow a bit before it enters another round of cell division In this lab, we’ll look at S cerevisiae cells under the microscope These yeast cultures will be in “log (short for logarithmic) phase,” when cells are dividing exponentially. Microscopy is one of the fun parts of working with yeast If you fix your cells, you can get a snapshot of the structures Live cells microscopy using fluorescent proteins tagged proteins is even better, as you can see the dynamics and cell machinery working before your own eyes Light Microscopy to Check for Contamination. Tap card to see definition 👆 When observed under the microscope, yeast cells appear larger than bacterial cells This is due to a) yeast cells swell more than they absorb stains b) yeast cells are eukaryotic c) yeast cells have multiple nuclei d) yeast cells have extremely thick cell walls.
The size of the bud, which will become the daughter cell, continues to grow until the cells divide in M phase When the cell divides, the daughter cell is still smaller than the mother cell The daughter cell will need to grow a bit before it enters another round of cell division In this lab, we’ll look at S cerevisiae cells under the microscope These yeast cultures will be in “log (short for logarithmic) phase,” when cells are dividing exponentially. From Yeast (White & Zainasheff) Microscope with 400X minimum magnification for counting yeast You want builtin illumination, adjustable condenser with aderture diaphragm control, mechanical stage, and binocular eyepiece Without x/y mechanical stgae controls, it is nearly impossibel to count cells. Has a budding cell Bacteria Small cells;.
Studies of thin sections of yeast cells (Saccharomyces cerevisiae) under the electron microscope have clarified our knowledge The cell wall contains protein, lipid, and at least two polysaccharides (a mannan and a glucan) Chitin has also been reported Immediately below the cell wall is the cytoplasmic membrane. Studies of thin sections of yeast cells (Saccharomyces cerevisiae) under the electron microscope have clarified our knowledge The cell wall contains protein, lipid, and at least two polysaccharides (a mannan and a glucan) Chitin has also been reported Immediately below the cell wall is the cytoplasmic membrane. 10 Everyday Things You Should Look at Under a Microscope 1 Cheek cells Cheek cells (more specifically, epithelial cells) form a protective barrier lining your mouth Due to 2 Onion skin The onion skin is a layer of protective epidermal cells against viruses and fungi that may harm the 3.
This will give you the magnification power to see bacterial cells and to observe differences in morphology of the bacterial cells This 100X objective lens requires the use of oil immersion, which I will explain in a future techniques post Another thing to consider is whether you want to take photos of what you see under the microscope. Materials Compound microscope One packet of active yeast Dropper or pipette 1 cup warm water Micrope slides and cover slips 1 tablespoon of sugar. ANSWER To observe the yeast under the microscope Place a drop of the yeast mixture on the microscope slide (it might be necessary to dilute it a bit more with water) Place a coverslip on top and observe under different magnifications High magnifications will be needed to see the yeast well.
Arranged in clusters or chains Respiration Yeast Ethanol fermentation Bacteria Either aerobic or anaerobic respiration Motility Yeast Immobile Bacteria Mobile with flagella Pili Yeast No pili Bacteria May have pili Reproduction. Using the microscope preparing the sample Since cells are counted only in a very small sample, the sample needs to be representative of the beer or liquid that contains the yeast population That means that the whole volume needs to be mixed very well and yeast cells cannot be allowed to flocculate This aspect is very important. May 26, 12 Yeast cells under the scanning electron microscope May 26, 12 Yeast cells under the scanning electron microscope Explore Art Contemporary Art Neo Conceptual Art Yeast cells under the scanning electron microscope Saved by Donna Hinson 30 More ideas for you Today.
The work involved viewing small groups of yeast cells repeatedly under a microscope and logging their behavior over time Additional analyses enabled the scientists to understand what happened. Two forms of yeast cells can survive and grow haploid and diploid The haploid cells undergo a simple lifecycle of mitosis and growth, and under conditions of high stress will, in general, die This is the asexual form of the fungus The diploid cells (the preferential 'form' of yeast) similarly undergo a simple lifecycle of mitosis and growth. IStock Yeast Under The Microscope Stock Photo Download Image Now Download this Yeast Under The Microscope photo now And search more of iStock's library of royaltyfree stock images that features Agar Jelly photos available for quick and easy download Product # gm $ 10 iStock In stock.
A single Yeast cell is typically about 3 to 4 micrometers in diameter but there are some species that can grow to be much larger, around 40 micrometers The Yeast cell is most commonly egg shaped or spherical although during periods of starvation different species of Yeast can take on different shapes. Yeast Cells Under The Microscope Baking Baker Fermentation Hd Stock Video 452 8 467 The Saccharomyces Cerevisiae World Daniel Seo Movement Dispersal 1 Scanning Electron Microscopy Image Of Saccharomyces Cerevisiae Winemaking Yeasts Play A Crucial Role In Your Wine S Flavor. A yeast cells swell more when they absorb stains b yeast cells are eukaryotic c yeast cells have multiple nuclei d yeast cells have extremely thick cell walls.
Under the microscope, Penicillium molds grow like a lawn with many fiberlike structures, called hyphae Some hyphae will branch and produce spores on their tips 5. This is where counting the yeast under a microscope comes in to determine the density of the yeast slurry (cells per unit volume) The counting chamber on the hemocytometer is a grid with a fixed height The grid is etched into a 5×5 pattern of 25 squares, each containing a 4×4 pattern within. Under the microscope are yeast of the genus saccharomyces Magnification X400 You can see dividing cells and nuclei Saccharomyces cerevisiae yeast budding cell under microscope Saccharomyces cerevisiae yeast budding cell under the microscope Saccharomyces cerevisiae yeast budding.
IStock Budding Yeast Cell Under The Microscope Stock Photo Download Image Now Download this Budding Yeast Cell Under The Microscope photo now And search more of iStock's library of royaltyfree stock images that features Ascomycete photos available for quick and easy download Product # gm $ 10 iStock In stock. Yeast cells are some of the smallest eukaryotic organisms with a diameter of only 5 to 10 micrometers per cell, and thus need to be viewed under high magnification optical microscopes, set to a high numerical aperture, resolution, and brightness. Materials Compound microscope One packet of active yeast Dropper or pipette 1 cup warm water Micrope slides and cover slips 1 tablespoon of sugar.
Under the Microscope Yeast Large cells;. While there are many types of Fungi, MicroscopeMaster will focus on mold under the microscope here Fungi is a taxonomic Kingdom that is composed of well over 99,000 species including yeast, molds, smuts and rusts among others. To observe the yeast under the microscope Place a drop of the yeast mixture on the microscope slide (it might be necessary to dilute it a bit more with water) Place a coverslip on top and observe under different magnifications High magnifications will be needed to see the yeast.
The final cellular feature we can (sometimes) see are yeast vacuoles – specialized organelles (technically lysosomes) which are acidfilled compartments inside of the yeast cell used to breakdown food and cell wastes Yeast can have a one or more vacuoles, and they can vary greatly in size Some yeast’s vacuoles are too small to be seen under a microscope, while others are so large that they occupy most of the interior space of the yeast Identifying vacuoles can help identify a yeast. Diagram Yeast Cell Under Microscope Written By MacPride Wednesday, March 14, 18 Add Comment Edit Yeast Fermentation Of Sugarcane For Ethanol Production Can It Be Cells Of V2 Yeast Isolate Under Microscope X100 Download Interactive Zooming In On Yeast. The concentration of yeast cells in the methylene blue solution will affect how easy it is to find the yeast when looking through the microscope Too few cells will mean each cell is far apart and.
Yeast cells that are budded are counted as one cell if the bud is less than onehalf the size of the mother cell If the bud is equal to or greater than onehalf the size of the mother cell, both cells are counted To obtain an accurate yeast cell count, it is advisable to count no fewer than 75 cells on the entire 1mm 2 ruled area and no more than. Yeast Cells Under The Microscope Baking Baker Fermentation Hd Stock Video 452 8 467 The Saccharomyces Cerevisiae World Daniel Seo Movement Dispersal 1 Scanning Electron Microscopy Image Of Saccharomyces Cerevisiae Winemaking Yeasts Play A Crucial Role In Your Wine S Flavor. Yeast cells that are budded are counted as one cell if the bud is less than onehalf the size of the mother cell If the bud is equal to or greater than onehalf the size of the mother cell, both cells are counted To obtain an accurate yeast cell count, it is advisable to count no fewer than 75 cells on the entire 1mm 2 ruled area and no more than.
1,768 yeast microscope stock photos, vectors, and illustrations are available royaltyfree See yeast microscope stock video clips of 18 beer yeast cell budding cell budding yeast yeast bacteria yeast cell microscope wine yeast beer yeast cells yeast cells yeasts yeast fungi Try these curated collections. The ultrastructure of yeast cells was first studied by transmission electron microscopy (TEM) using thin sections in 1957 , and the freezeetching replica method was introduced in 1969;. Using a diploid lager yeast strain Barker and Smart (1996) reported that the mean cell volume of virgin daughter cells was approximately 150 um3 Cells, which had undergone around rounds of budding and where approaching the end of their life spans, had mean cell volumes of approximately 850 um3.
Yeast, Saccharomyces ellipsoideus, seen under a microscope, at x710 magnification Candida Albicans baking yeast cells yeast microscope stock pictures, royaltyfree photos & images yeast, sem yeast microscope stock pictures, royaltyfree photos & images. When observed under the microscope, yeast cells appear larger than bacterial cells This is due to a) yeast cells swell more than they absorb stains b) yeast cells are eukaryotic c) yeast cells have multiple nuclei d) yeast cells have extremely thick cell walls. Yeast Under the Microscope Obtain yeast cake (this can be bought from bakery specialty stores or a supermarket) Cut a small piece of yeast cake and mix with water to form a pasty texture Add a little more water to form a solution Using a dropper, collect and place a drop of the solution on a.
Diagram Yeast Cell Under Microscope Written By MacPride Wednesday, March 14, 18 Add Comment Edit Yeast Fermentation Of Sugarcane For Ethanol Production Can It Be Cells Of V2 Yeast Isolate Under Microscope X100 Download Interactive Zooming In On Yeast. Using the microscope preparing the sample Since cells are counted only in a very small sample, the sample needs to be representative of the beer or liquid that contains the yeast population That means that the whole volume needs to be mixed very well and yeast cells cannot be allowed to flocculate This aspect is very important. 1,768 yeast microscope stock photos, vectors, and illustrations are available royaltyfree See yeast microscope stock video clips of 18 beer yeast cell budding cell budding yeast yeast bacteria yeast cell microscope wine yeast beer yeast cells yeast cells yeasts yeast fungi Try these curated collections.
Yeast cells that are budded are counted as one cell if the bud is less than onehalf the size of the mother cell If the bud is equal to or greater than onehalf the size of the mother cell, both cells are counted To obtain an accurate yeast cell count, it is advisable to count no fewer than 75 cells on the entire 1mm 2 ruled area and no more than. Cells under a microscope but have found use outside of hematology Commonly, the improved Neubauer haemocytometer is found in the brewing industry, as it is specified in standardised yeast counting methods9 The counting chamber is divided into nine large squares and the middle square is subdivided into 25 smaller squares which are further. The mixture was incubated for 1 minute at room temperature, and 10 μl of 5% yeast cell suspension was added immediately to the mixture The mixture was incubated for 10 additional minutes at room temperature, mixed again, applied to a glass slide and observed under a Levenhuk microscope Pictures were taken with a DEM135 camera (Levenhuk).
Examination of the discharge under a microscope is the simplest and least costly method used for diagnosis of yeast infection, but this test may be negative in up to 50% of women who have a yeast infection In some cases, the doctor may administer a Pap test to rule out the possibility of cervical dysplasia or cancer. Yeast are singlecelled microorganisms classified as eukaryotic cells Which just means the Yeast cell has membrane encased organelles A single Yeast cell is typically about 3 to 4 micrometers in diameter but there are some species that can grow to be much larger, around 40 micrometers. This is where counting the yeast under a microscope comes in to determine the density of the yeast slurry (cells per unit volume) The counting chamber on the hemocytometer is a grid with a fixed height The grid is etched into a 5×5 pattern of 25 squares, each containing a 4×4 pattern within.

Shutterstock Puzzlepix

656 Yeast Cell Photos Free Royalty Free Stock Photos From Dreamstime

Yeast Cells High Resolution Stock Photography And Images Alamy
Yeast Cells Under Microscope のギャラリー

Yeast Wikipedia

Budding Yeast Cell Microscope Stock Photo C P Thongdumhyu

Engineering Com Hybrid Technology Converts Sugar Into Nylon

Cellular Fractionation Yeast Cells Sciencedirect
Budding Yeast Cell Microscope Stock Photo C P Thongdumhyu

Trichomonas Vaginalis Bacteria And Yeast Cells Under The Microscope Youtube

Active Beer Yeast Video 400x Magnification Homebrewing Home Brewers Blog

Budding Yeast Cell Under The Microscope Stock Video Download Video Clip Now Istock

Techniques Using A Microscope To Explore Fermented Foods Microbialfoods Org

Budding Yeast Stock Video Footage 4k And Hd Video Clips Shutterstock

How Yeast Formations Got Started Doe Joint Genome Institute
3

Budding Yeast Cell Microscope Stock Photo C P Thongdumhyu

Yeast Definition Uses Britannica

Top Tips For Yeast Microscopy

Yeast Morphology Primer Yeast Under The Brewery Microscope
Q Tbn And9gctdxstmw4hl5lhphztyzp87yhdkw1pwqfs9g5me1tjlt S7tzbd Usqp Cau

Yeast Cells Stock Image Image Of Laboratory Illness

Yeast Microscope Hd Stock Images Shutterstock

Yeast Cells Under The Microscope Characteristics Habitat Observation

57 Budding Of Yeast Cells Youtube

Microscope World Blog 15

Meet Baker S Yeast The Budding Single Celled Fungus That Fluffs Your Bread University At Buffalo

Yeast Cells High Resolution Stock Photography And Images Alamy

Signaling In Yeast Biology For Majors I

Observing Yeast Under The Microscope Microscope Club

Budding Yeast Cells With Pseudohyphae In Urine Sample Fine With Stock Photo Picture And Royalty Free Image Image

Budding Yeast Cell Under The Microscope Stock Photo Download Image Now Istock

Yeast Cells Under The Microscope Youtube

Direct Yeast Cell Count At Od600 Tip Biosystems

10 Everyday Things You Should Look At Under A Microscope Rs Science

Budding Yeast Cell Under The Microscope Stock Video Download Video Clip Now Istock

Microscope Image Of Mature Yeast Culture At High Magnification Download Scientific Diagram

Yeast Cells Under Microscope View Stock Photo Picture And Royalty Free Image Image
Q Tbn And9gctcdzi Vf7p4k0olcphoemovh Vlzdnc7kxzuqghjwejulnknfy Usqp Cau

Active Beer Yeast Video 400x Magnification Homebrewing Home Brewers Blog

How To Do A Yeast Cell Count
Yeast Exp Pictures

Saccharomyces Yeast Cells Nikon S Microscopyu

Fungi Lab Biology Libretexts
The Green Component Of A Microscopic Image Of A Budding Yeast Cell Download Scientific Diagram

Pics Of Yeast Under My New Microscope Homebrewtalk Com Beer Wine Mead Cider Brewing Discussion Community

Branching Budding Yeast Cells With Pseudohyphae In Urine Sample Stock Photo Picture And Royalty Free Image Image

Yeast Cells Under The Scanning Electron Microscope Medical Technology Medical Technology Labs Medical Design

Cell Structure Learning Intention Ppt Video Online Download

Yeast Wikipedia

Bright Field Microscopy Image Of Yeast Cells Including Sand Particles Download Scientific Diagram

Yeast Under Microscope Images Stock Photos Vectors Shutterstock

Microscope Use In Brewing German Brewing And More

Microscope World Blog Kids Science Microscope Activity Yeast

Microscope Use In Brewing German Brewing And More

Yeast Cells Stock Image Image Of Cerevisiae Form Background

Budding Yeast Cell Under The Microscope Stock Photo Download Image Now Istock

Yeast Infection Candidiasis My Doctor Online

Budding Yeast Cell Under Microscope Stock Photo Edit Now

How Yeast Makes Heads Or Tails Of Itself

Austrian Researchers Turn Baker S Yeast Into Biodiesel Agro Chemistry

Microscopy Of Fission Yeast Sexual Lifecycle Protocol

Scientists Engineer Baker S Yeast To Produce Penicillin Molecules Imperial News Imperial College London

Budding Yeast Cells In Urine Analyze By Microscope Buy This Stock Photo And Explore Similar Images At Adobe Stock Adobe Stock
Budding Yeast Cells Why They Matter And Why You Should Count Them

Saccharomyces Yeast Cells Nikon S Microscopyu

Baker S Yeast Under The Microscope Youtube

Yeast Cells Tem Stock Image B250 1678 Science Photo Library

Techniques Using A Microscope To Explore Fermented Foods Microbialfoods Org

59 Yeast Microscope Photos And Premium High Res Pictures Getty Images

Collins Lab Blog Life In The Collins Lab

A A Dic Microscope Image Of Yeast Cells B Segmentation Results Download Scientific Diagram

Budding Yeast Cell Under The Microscope Stock Photo Download Image Now Istock

Mycology Introduction

Light Microscopy Of The G2 Yeast Fast Moving Intracellular H Pylori Download Scientific Diagram

Yeast Cells Academy Of Aerospace And Engineering

Vaginal Yeast Infections Taste For Life

Yeast Cells Cell Biology Quatr Us Study Guides

Yeast Cells Under The Microscope Characteristics Habitat Observation Tiredness Remedies Candida Migraines Remedies

Yeast Cells Under Microscope View Stock Photo Picture And Royalty Free Image Image

Solved Ligu 2 Once Focused On Scanning And Lower Powers Chegg Com

Bacteria Can Determine The Flavour Of Wine

Fission Yeast Cells As Seen Under A Microscope Okinawa Institute Of Science And Technology Graduate University Oist

Baker S Yeast Wikipedia

Epithelial Tissue With Bacteria Cells Yeast Cells Epithelial Tissue With Bacteria Yeast Cells In Urine Sample Under Canstock

Budding Yeast Cells Why They Matter And Why You Should Count Them

Yeast Under Microscope Photos Free Royalty Free Stock Photos From Dreamstime

Budding Yeast Cell Under Microscope Stock Photo Edit Now

Yeast Unc Lineberger

The Open Door Web Site Biology Living Without Oxygen Anaerobic Respiration
Yeast Cells Dividing Under The Microscope Baker S Yeast Video Dailymotion

Yeast Cells Microcosmos

Yeast Call Me Dad Decanter China 醇鉴中国

Microbial Diversity Of Kombucha Microbialfoods Org

Microscopy Eureka Brewing

Yeast Cells Imaged By Microscopy A S Cerevisiae B T Delbrueckii Download Scientific Diagram

Team Gothenburg Parts Results 14 Igem Org

Mycology Introduction

Yeast Bubbles Experiments On Microscopes 4 Schools

Yeast Cells Under Microscope View Stock Photo Picture And Royalty Free Image Image

A Star Is Born

Scanning Electron Microscope Blog April 13

Scanning Electron Microscope Blog April 13
Yeast Cells Stock Video Footage Royalty Free Yeast Cells Videos Pond5



